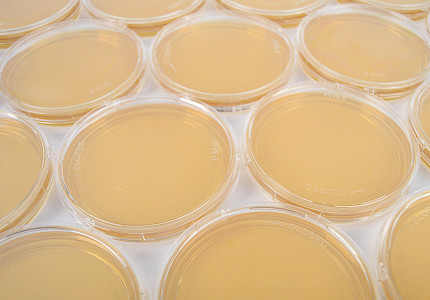

Petrischalen
Ob selektive Nährmedien oder für das Hygienemonitoring, 1-fach- oder 3-fach verpackt, gamma bestrahlt – hier werden Sie fündig.
Diese Website verwendet Cookies
Notwendige Cookies helfen dabei, eine Webseite nutzbar zu machen, indem sie Grundfunktionen wie Seitennavigation und Zugriff auf sichere Bereiche der Webseite ermöglichen. Die Webseite kann ohne diese Cookies nicht richtig funktionieren.
Name | Anbieter | Zweck | Ablauf |
---|---|---|---|
wire | pmm-leimen.de | Der Cookie ist für die sichere Anmeldung und die Erkennung von Spam oder Missbrauch der Webseite erforderlich. | Session |
cmnstr | pmm-leimen.de | Speichert den Zustimmungsstatus des Benutzers für Cookies. | 1 Jahr |
Statistik-Cookies helfen Webseiten-Besitzern zu verstehen, wie Besucher mit Webseiten interagieren, indem Informationen anonym gesammelt und gemeldet werden.
Name | Anbieter | Zweck | Ablauf |
---|---|---|---|
_ga | Registriert eine eindeutige ID, die verwendet wird, um statistische Daten dazu, wie der Besucher die Website nutzt, zu generieren. | 2 Jahre | |
_gat | Wird von Google Analytics verwendet, um die Anforderungsrate einzuschränken. | 1 Tag | |
_gid | Registriert eine eindeutige ID, die verwendet wird, um statistische Daten dazu, wie der Besucher die Website nutzt, zu generieren | 1 Tag |
Die Pharmamedia Dr. Müller GmbH wurde erst vor wenigen Jahren gegründet und hat sich als führender Anbieter von Nährmedien für die pharmazeutische Industrie in Europa etabliert. Das Ziel unseres erfahrenen Teams ist es, qualitativ hochwertige, innovative Medien, die unter pharmazeutischen Bedingungen hergestellt werden, in Kombination mit zuverlässigem Service und Flexibilität anzubieten.
Ob selektive Nährmedien oder für das Hygienemonitoring, 1-fach- oder 3-fach verpackt, gamma bestrahlt – hier werden Sie fündig.
Ob Infusionsflaschen oder Flaschen mit Schraubverschluss....
Besondere Kunden erfordern besondere Lösungen. Wir freuen uns auf Ihre Herausforderung.
Lassen Sie uns zusammen die richtige Lösung für Sie finden. Wir freuen uns auf Ihre Herausforderung.
AnfrageDie PharmaMedia Dr. Müller GmbH ist am 16.01.2013 von Herrn Dr. Rolf Müller gegründet worden. Dr. Rolf Müller hat 1973 die heipha Dr. Müller GmbH gegründet und leitete über 30 Jahre erfolgreich das Unternehmen. Nach seinem Ausscheiden entschied er sich für einen Neuanfang. Jetzt wird erneut der Schwerpunkt auf die Produktion von qualitativ hochwertigen Nährmedien für die pharmazeutische Industrie gelegt. Mit einem kompetenten Team aus erfahrenen Mitarbeitern bietet die PharmaMedia Dr. Müller GmbH unseren Kunden Produkte mit einem entsprechenden Service.